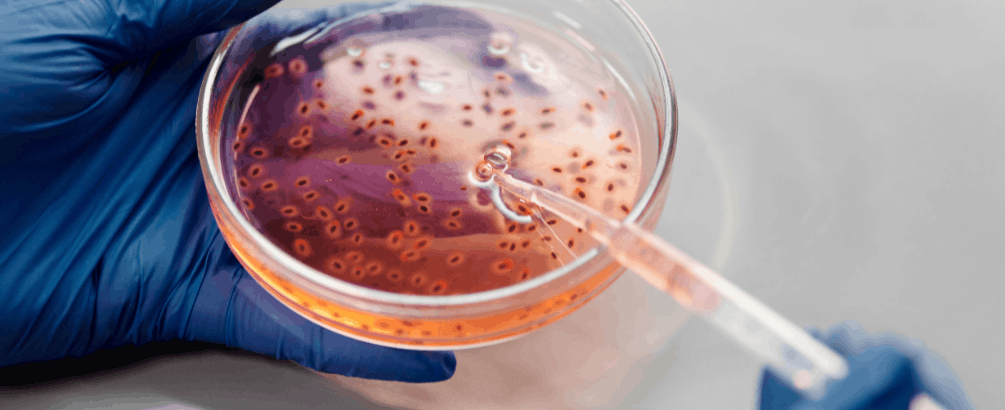
Brain-Eating Amoeba: What Singapore Residents Need to Know

The brain-eating amoeba, or Naegleria fowleri in scientific terms, is a microscopic organism that survives in a warm and fresh water environment. The amoeba is responsible for a rare but extremely serious infection called
primary amoebic meningoencephalitis (PAM) , which results in severe brain inflammation.
Although this is an extremely rare occurrence, this infection is almost always fatal. Considering that Singapore is a tropical country with a constant temperature, it is essential that its citizens are aware of this and take the required precautions to ensure their safety.
What Is Brain-Eating Amoeba and Where Does It Live?
The brain-eating amoeba,
Naegleria fowleri , resides in a warm and fresh water environment, including lakes, rivers, ponds, hot springs, and swimming pools that are poorly disinfected. This amoeba survives in temperatures that range from 25°C to 46°C.
Although this is an extremely rare occurrence in Singapore due to its stringent standards of water treatment and disinfection, as enforced by PUB (Public Utilities Board), other sources of fresh water could be potential health hazards.
The amoeba is inhaled when contaminated water is forced upwards through the nostrils, usually while swimming or rinsing the nostrils. It reaches the brain and resides there. It is essential to note that drinking contaminated water does not cause this infection.
How to Protect Yourself: Essential Prevention Tips
Avoid Warm Freshwater During Peak Heat
Swim in fresh water that is not extremely warm and avoid swimming in fresh water during peak heat. This is because an increase in temperature is an essential requirement for the survival of this amoeba.
Keep Your Head Above Water
Avoid diving, jumping, or submerging your head in the water. Since amoeba infects the body through the nasal passage, keeping your head above the water minimizes the risk of amoeba infection.
Use Nose Clips or Hold Your Nose Closed
When swimming in fresh water, using nose clips or keeping your nose closed can help prevent amoeba from entering the nasal passage.
Avoid Stirring Up Sediment
Since amoeba infests the sediment at the bottom of the lake or river, it is advisable to avoid digging or stirring the sediment.
Shower After Swimming
Taking a shower after swimming can help reduce the chances of amoeba infection because the amoeba on your skin or hair will not infect the nasal passage.
Use Only Safe Water for Nasal Rinsing
Never use tap water for nasal rinsing or neti pots. Always boil the water or filter it.
Follow Local Water Advisories
When visiting Southeast Asia, it is advisable to check the advisories on the safety of the water before swimming.
Why Home Water Filtration Matters for Amoeba Prevention
While the tap water supply in Singapore is considered one of the safest in the world, certain activities at home, such as nasal rinsing or sinus irrigation, may increase the risk of infection if untreated water is used. Using
reverse osmosis water filtration systems at home can act as an added layer of protection. Reverse osmosis systems are designed to filter bacteria, protozoa, viruses, heavy metals, chlorine, and other contaminants from the water, making it highly purified for household use.
Water Safety Tips
- Boil tap water before nasal rinsing
- Ensure that swimming pools in the neighborhood are properly chlorinated
- Avoid swimming if suffering from nasal congestion or sinus infection
- Teach children the importance of safe swimming practices
Frequently Asked Questions (FAQs)
What is brain-eating amoeba?
A brain-eating amoeba is a microscopic pathogen that can cause a deadly brain infection if contaminated water is inhaled while swimming in a pool that is not well-chlorinated.
How common are infections in Singapore?
Infections in Singapore are very rare because of the stringent standards that the authorities maintain in the water treatment process.
Can I get infected by drinking contaminated water?
No. Infection can only happen if the contaminated water enters the nasal passages. Drinking the contaminated water is not the cause.
How can I reduce my risk while swimming?
Avoid warm freshwater, keep your head above the water, use nose clips, and do not stir the sediment in the water.
Is tap water safe for nasal rinsing in Singapore?
For health and safety, it is recommended to use only boiled, distilled, or filtered water for nasal rinsing.
Does showering after swimming reduce my risk?
Yes. Showering after swimming removes microbes from your body and hair.
How effective are reverse osmosis filtration systems?
Reverse osmosis systems can be highly effective in the purification process and may help remove bacteria, viruses, and other impurities, including amoebas, from water.
Why choose Waterdrop RO systems?
Waterdrop RO systems are designed to be efficient in purification, compact, and safe, making them suitable for Singaporean homes.
What should I do if I suspect an infection?
If you suspect you might be infected, seek medical help immediately. Early detection is important since the illness is quite serious.
Conclusion
Despite the rarity of this infection, it is important to stay informed and take the necessary precautions to reduce potential risks. With proper knowledge and safe water practices, including the use of high-quality reverse osmosis systems, Singapore residents can minimize exposure risks and feel more confident about their household water use.